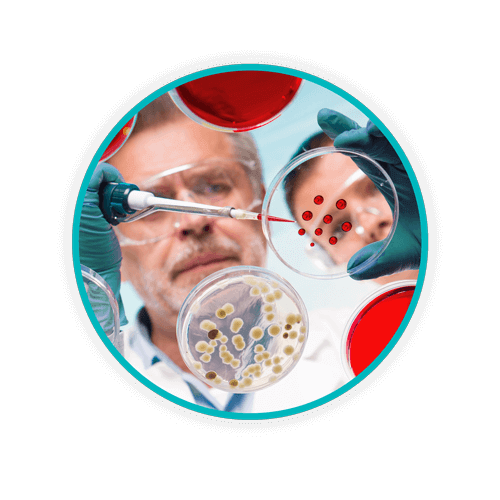
Blog Body Petri Cultures WEB

Regulated Medical Waste: 5 Things That Are Surprisingly Not Regulated

The “better safe than sorry” approach shouldn’t apply to certain things – like disposing of something as Regulated Medical Waste (RMW) when it may not be RMW. In this blog, explore some common errors that clinicians can make that result in errantly mixed waste streams.
You might be surprised to find a number of things that you think are regulated medical waste, but they’re not.
A number of online resources describe different waste categories, as well as terminology, definitions, and descriptions proposed by federal regulations and state and local guidelines. Different states use different terms that are often confusing, such as the difference (or similarity) between regulated medical waste (RMW), hazardous, biohazard waste, infectious waste, and other waste streams. The same holds true when it comes to regulated and non-regulated waste.
It gets confusing when states use different terms to describe the same thing. For example, did you know that regulated medical waste is also known as infectious waste and/or biohazardous waste? Overall, the basic definition of regulated medical waste is “the portion of a waste stream that may be contaminated by blood, body fluids, or other potentially infectious materials, thus posing a significant risk of transmitting infection.”

The Occupational Safety and Health Administration (OSHA) categorizes medical waste as:
- A semi- liquid blood or other potentially infectious material (OPIM);
- Items that have been contaminated with blood or OPIM that would release these substances in a liquid or semi liquid state if compressed;
- Items that are caked with dried blood OPIM capable of releasing these materials during handling;
- Pathological and microbiological wastes containing blood or OPIM
Add to that confusion in terminology to the guidelines recommended by state governments including Departments of Health, environmental resources, and local or town ordinances. Most states follow regulations for medical waste based on Environmental Protection Agency and OSHA standards, although the standards for medical waste management differ greatly.
In the majority of states, the Environmental Protection Agency (EPA) is the entity responsible for the development and enforcement of medical waste management and disposal regulations, although some states are under the control of the Department of Health.
Okay, now that that’s settled, what commong items are not to be regulated medical waste?
Five things are surprisingly not regulated medical waste
Healthcare waste segregation and management relies on the education and knowledge of healthcare professionals. Your employees must be able to identify different waste stream categories and separate all medical waste in an appropriate manner to maintain compliance with federal and state guidelines.
A number of items that healthcare professionals and facility employees may deem regulated medical waste (based on definitions categorizing such waste) but are not, include:
- Urine or feces
- Vomit
- Nasal discharge or mucus (sputum)
- Saliva – (unless exposed during dental procedures)
- Sweat
These are not deemed regulated unless they contain blood or other infectious bodily fluids – and that implies blood that can be ‘squeezed’ or blood that drips or flakes after it’s dried. A number of examples of RMW include but is not limited to bandages and dressings, personal protective equipment, suction canisters, surgical gloves, IV equipment and tubing, and cultures, stocks, and swabs used to inoculate cultures.
Another common error are clinicians disposing of urine sample cups in RMW waste – again this is not RMW. This is often done with the good intent to destroy patient information that may be on the cup, but your facility has better processes to do that. When waste is put put in RMW bins that doesn’t belong it endangers compliance, efficiency, sustainability, and costs!
Sharps waste, defined as any object that is capable of penetrating or cutting skin, can include anything from scalpels to suture needles, syringes with needles, butterflies, razor blades, and trocars, among others. Yes, there always has been, and likely always will be, some confusion regarding definitions when it comes to regulated medical waste and what is and what isn’t unless healthcare providers are well-versed in the regulations and guidelines.
Important note to remember: Not all bodily fluid wastes are regulated medical waste. You may think that anything that has come into contact with blood is regulated medical waste, but it isn’t. Again, it all comes down to wording; for example, the word “saturated”. If it’s not “saturated” ask yourself these questions: Does the object contain liquid or semi-liquid blood? Does the “blood-soaked” item release blood if it’s squeezed? If the answer is no, it’s not ‘saturated’.
Vomit, feces, and urine as well as non-liquid or solidified blood are not typically considered regulated waste based on state or federal waste guidelines. If an item is “caked” with blood, according to OSHA regulations, it can be defined as a regulated medical waste, but only if it’s capable of “releasing” caked, dried blood or OPIM during handling. The same is applicable to items contaminated with blood or OPIM, which would release infectious or biohazardous substances “in a liquid or semi liquid state if compressed”, again based on OSHA standards.
State regulations define RMW categories
State regulations differ slightly in wording, but typically used – and general definitions – for regulated medical waste include:
- Pathological waste
- Human blood and blood products
- Cultures and stocks of infectious agents (a.k.a. microbiological waste)
- Contaminated sharps
- Isolation waste
If in doubt, refer to state and federal guidelines regarding the difference between regulated medical waste and infectious waste, anatomical waste, pathological waste, or surgical waste. Waste segregation and identification of waste stream categories is essential in properly identifying and separating different types of medical waste.
Of course, it’s always recommended that healthcare professionals take adequate precautions when cleaning up bodily fluids, whether it’s, vomit or items saturated with saliva. Be aware that a number of bodily fluids such as vaginal secretions, semen, synovial fluid, cerebrospinal fluid, among others, are not generally considered biohazard waste unless it’s been contaminated with blood.
Some OPIMs within the medical industry can be potentially infectious, but again, based on terminology and definitions, are not listed under the category of RMW. Be cautious, protect yourself, and dispose of healthcare waste properly.
Daniel Health knows the difference
Daniels Health provides resources, education, and products that take the guesswork out of medical waste segregation. Healthcare waste stream identification is essential to maintaining the safety of healthcare providers. Proper healthcare waste management ensures that you and your facility maintain compliance to federal, state and local guidelines when it comes to medical waste disposal. For more information on how Daniels Health can provide support, products, and solutions for your medical waste management challenges, call us today.
Let's Talk!
Your time is valuable, and we don’t want to play hard to get. You can either phone us directly on the details listed on our contact page, or feel free to fill out this short form and one of our team members will get back to you as quickly as possible.
